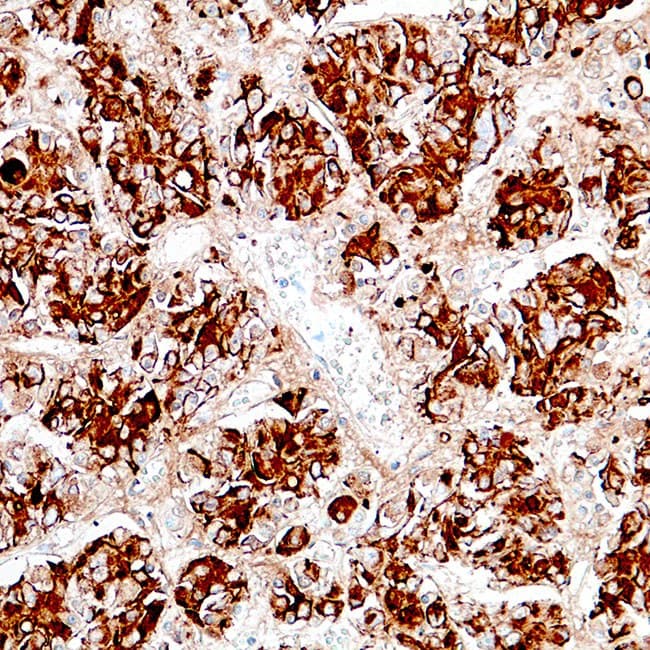

Anti-Prolactina CE/IVD para IHC - Neuropatologia
Prolactina (PRL) é uma hormona peptídeo sintetizada e secretada por células lactotróficas na adenohypophysis (glândula pituitária anterior) que é necessária para a proliferação e diferenciação das glândulas mamárias. O PRL desempenha um papel em vários processos, incluindo o crescimento celular, reprodução e função imunológica, sendo a sua função primária associada à lactação. Prolactina também actua de uma forma semelhante à citocina e como um importante regulador do sistema imunitário. A prolactina tem importantes funções relacionadas com o ciclo celular como factor de crescimento, diferenciador e anti-apoptótico. Prolactina é secretada por lactotróficos na pituitária anterior. As células produtoras de prolactina constituem aproximadamente 20 por cento da pituitária. Foram observadas contagens elevadas destas células em mulheres grávidas, recém-nascidos e em mulheres multiparosas. A anti-prolactina reage com células lactotróficas, e é útil na classificação dos tumores pituitários e no estudo da doença pituitária.
Secção da glândula hipofisária
Resultado da sua pesquisa : 3 produto encontrado
Refine sua procura :
RUO
CE/IVD
NEW
- Unconjugated 3
- human 3
- mouse 3
- Primary antibody
- IHC 3
- IHC652 3
Referência
Descrição
Cond.
Price Bef. VAT
‹
›
